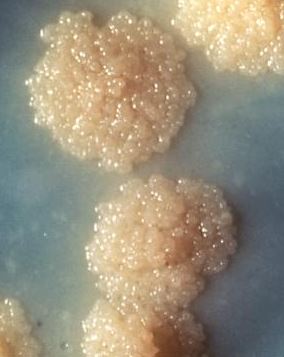

Туберкулез Кур Фото
Запеченные Тарталетки Рецепты С Фото
Рисовать Картинки Перевод
Наташа Фото Приватное
Чертенок 13 Фото
Эстель Светло Русый Пепельный Фото
Творожные Маффины Фото
Оляша Слив Фото 2025
Переделать Фото В Хорошем Качестве
Дизайн Кухонных Дверей Фото
Фото Голых Красивых Женщин 55 Лет
Доброго Вечера И Хороших Выходных Картинки
Алены Фото Дети
Это Странное Фото Было
Туберкулез Кур Фото 115 фото